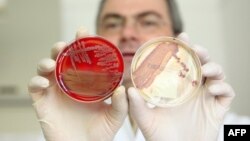

Silver has been used since antiquity for its antibacterial properties, but little has been known about how it works to combat infection.
Now, scientists have shown that adding tiny amounts of silver to antibiotics makes them 10 to 1,000 times more effective at fighting infections.
A team of U.S. researchers reported this week in the journal "Science Translational Medicine" that experiments both in vitro and in mice have discovered that silver makes the bacteria's membrane more permeable to antibiotics. The metal also leads to the overproduction of reactive, and often toxic, oxygen compounds that abet the death of the bacteria.
Dr. Jim Collins of Boston University, one of the authors of the study, tells RFE/RL that both mechanisms restore antibiotic susceptibility to a resistant bacterial strain.
He says silver could potentially make today's antibiotics more effective against antibiotic resistance.
"Silver has been used for millennia as a stand-alone antibacterial, going back to the ancient Egyptians and ancient Greeks," Collins says. "What our work is showing is that, in fact, maybe it's worthwhile to think about silver in a different manner but nonetheless still as a weapon and a tool against resistant bacteria. And that is -- silver could be used in very small or trace amounts as a booster of our currently and commonly used antibiotics."
'Growing Crisis'
Silver acts against Gram-negative bacteria, one of the two main types of bacteria, which are increasingly resistant to most available antibiotics.
Gram-negative bacteria cause infections such as pneumonia, bloodstream infections, wound or surgical-site infections, and meningitis in health-care settings.
Collins says the dramatic growth of antibiotic-resistant strains has made it imperative to develop new antimicrobial therapies.
"It's really a major and growing crisis due to wide use and in many cases overuse of antibiotics," he says. "The number of resistant strains in our hospitals and now in our communities is dramatically growing. This problem is unfortunately coupled with a concerning trend, and that is the number of new antibiotics being developed and approved is significantly dropping. And, as a result, we're facing a crisis where we may soon not have effective weapons to treat many of the infections that people could obtain."
Concerns About Toxicity
Future research is expected to focus on testing how silver can be added, for instance, to antibiotic tablets for use in patients.
The new study suggests silver will be safe to use in very small amounts with existing antibiotics.
But Dr. Ruth McNerney, a senior lecturer in Pathogen Biology and Diagnostics at the London School of Hygiene and Medicine, says that scientists will have to address the metal's toxicity very carefully before adding silver to antibiotics.
"We're not sure what the toxicity of silver would be in terms of will it damage people's kidneys or their liver," McNerney says. "And it also might then make the antibiotics more toxic, as well. So until longer-term studies are done, we really won't have answers to those questions. But it is a very interesting study."
McNerney says she does not think the price of silver will be a big issue given the tiny amounts of the precious metal that would be used in possible treatments.
Now, scientists have shown that adding tiny amounts of silver to antibiotics makes them 10 to 1,000 times more effective at fighting infections.
A team of U.S. researchers reported this week in the journal "Science Translational Medicine" that experiments both in vitro and in mice have discovered that silver makes the bacteria's membrane more permeable to antibiotics. The metal also leads to the overproduction of reactive, and often toxic, oxygen compounds that abet the death of the bacteria.
Dr. Jim Collins of Boston University, one of the authors of the study, tells RFE/RL that both mechanisms restore antibiotic susceptibility to a resistant bacterial strain.
He says silver could potentially make today's antibiotics more effective against antibiotic resistance.
"Silver has been used for millennia as a stand-alone antibacterial, going back to the ancient Egyptians and ancient Greeks," Collins says. "What our work is showing is that, in fact, maybe it's worthwhile to think about silver in a different manner but nonetheless still as a weapon and a tool against resistant bacteria. And that is -- silver could be used in very small or trace amounts as a booster of our currently and commonly used antibiotics."
'Growing Crisis'
Silver acts against Gram-negative bacteria, one of the two main types of bacteria, which are increasingly resistant to most available antibiotics.
We're facing a crisis where we may soon not have effective weapons to treat many of the infections that people could obtain.
Collins says the dramatic growth of antibiotic-resistant strains has made it imperative to develop new antimicrobial therapies.
"It's really a major and growing crisis due to wide use and in many cases overuse of antibiotics," he says. "The number of resistant strains in our hospitals and now in our communities is dramatically growing. This problem is unfortunately coupled with a concerning trend, and that is the number of new antibiotics being developed and approved is significantly dropping. And, as a result, we're facing a crisis where we may soon not have effective weapons to treat many of the infections that people could obtain."
Concerns About Toxicity
Future research is expected to focus on testing how silver can be added, for instance, to antibiotic tablets for use in patients.
The new study suggests silver will be safe to use in very small amounts with existing antibiotics.
But Dr. Ruth McNerney, a senior lecturer in Pathogen Biology and Diagnostics at the London School of Hygiene and Medicine, says that scientists will have to address the metal's toxicity very carefully before adding silver to antibiotics.
"We're not sure what the toxicity of silver would be in terms of will it damage people's kidneys or their liver," McNerney says. "And it also might then make the antibiotics more toxic, as well. So until longer-term studies are done, we really won't have answers to those questions. But it is a very interesting study."
McNerney says she does not think the price of silver will be a big issue given the tiny amounts of the precious metal that would be used in possible treatments.